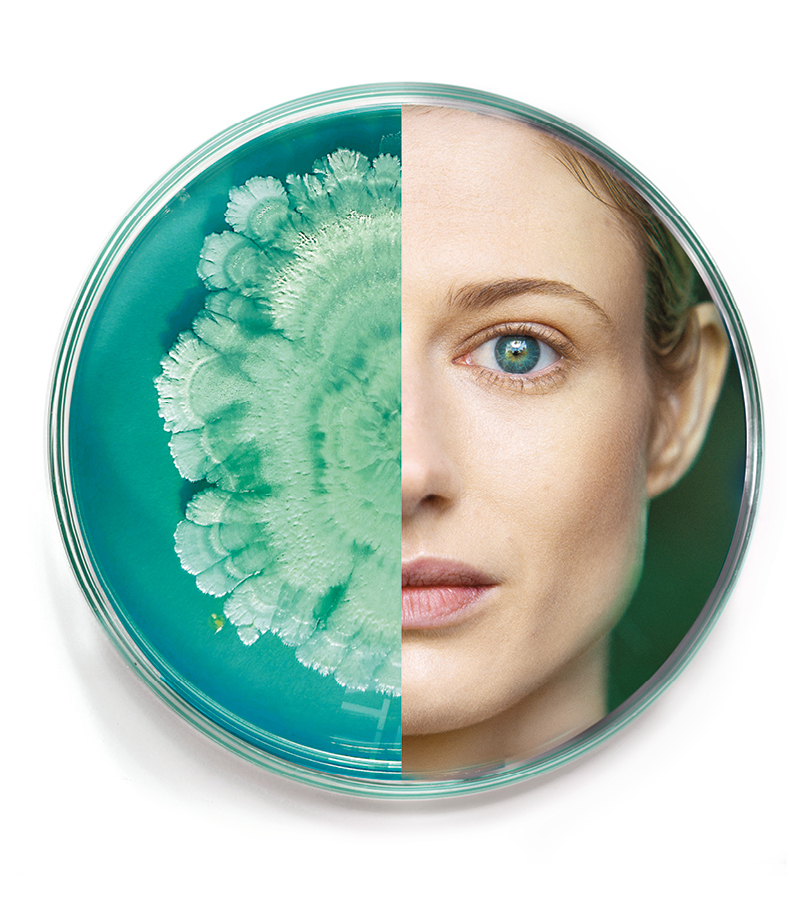
Organic Facials at Luxe Laser & Aesthetics of Woodbridge, Virginia

Luxe Facial Services
Organic Skincare That Works With Your Skin, Not Against It!
ABOUT OUR LUXE FACIAL SERVICES
At Luxe Laser & Aesthetics of Woodbridge, Virgina, we proudly use Esse Skincare a certified organic, vegan, and microbiome friendly line to elevate every facial experience.
Esse is unlike conventional skincare brands because it focuses on supporting the skin's natural microbiome, the ecosystem of beneficial microbes that protect, nourish, and balance the skin. Instead of stripping the skin or using harsh chemicals, Esse products use prebiotics, probiotics, and postbiotics to create a healthy environment on the skin's surface, allowing the skin to naturally regenerate and strengthen.
What makes our spa unique is not only our commitment to clean, sustainable beauty, but also our customized approach using Esse's advanced formulations. Whether you're dealing with sensitivity, breakouts, dryness, or signs of aging, we tailor every facial to your skin's specific needs using the power of nature and science combined.
By choosing Esse, we're not just treating the skin, we're working with it, respecting its biology, and promoting genuine, lasting health from the inside out.

Custom Facial Services
Book Now →Custom Luxe Facial: 60 min: $115
The Custom Deluxe Facial is a tailored treatment designed to reset and refresh your skin. Featuring deep cleansing, light exfoliation, targeted mask therapy, and a personalized selection of finishing products, this facial addresses your main skin concerns with a more traditional, yet results driven approach. Ideal for maintaining healthy, balanced skin with a luxurious feel, without the inclusion of specialized tools.
Custom Deluxe Facial: 90 min: $150
Our Custom Deluxe Facial offers an elevated experience for skin in need of deep rejuvenation. This treatment is fully personalized, blending advanced techniques and premium skincare to target your specific concerns whether it's hydration, brightening, firming, or calming. Includes double cleansing, gentle exfoliation, extractions (if needed), custom masks, and specialized tools such as photon LED therapy, microcurrent, or ultrasonic infusion for enhanced results. Perfect for those seeking a next-level, skin-transforming experience with a luxurious touch.
Teen Facial: 60 min: $75
Perfect for young, developing skin ages 13-18, our Teen Clean Facial is designed to target breakouts, balance oil production, and build healthy skincare habits. This gentle yet effective treatment includes a deep cleanse, light exfoliation, extractions (if needed), facial massage, a calming mask, and finishing products tailored to your skin's needs.
Mama Glow Facial: 60 min: $95
Our Mama Glow Facial is a deeply soothing, pregnancy safe treatment designed to pamper and support expecting mothers through every stage of their journey. Using only natural, non-toxic, and pregnancy safe products, this facial calms hormonal skin changes while promoting a healthy, radiant glow.
Custom Facial Services Comparison
| Feature | Custom Luxe | Custom Deluxe | Teen Facial | Mama Glow |
|---|---|---|---|---|
| Treatment Duration | 60 minutes | 90 minutes | 60 minutes | 60 minutes |
| Description | Tailored treatment to reset and refresh your skin | Elevated experience for deep rejuvenation | Perfect for young, developing skin ages 13-18 | Pregnancy safe treatment for expecting mothers |
| Key Features | Deep cleansing, light exfoliation, targeted mask therapy | LED therapy, microcurrent, ultrasonic infusion | Targets breakouts, balances oil production | Natural, non-toxic, pregnancy safe products |
| Best For | Maintaining healthy, balanced skin | Skin-transforming experience | Building healthy skincare habits | Calming hormonal skin changes |
| Price | $115 | $150 | $75 | $95 |
- Treatment Duration
- 60 minutes
- Description
- Tailored treatment to reset and refresh your skin
- Key Features
- Deep cleansing, light exfoliation, targeted mask therapy
- Best For
- Maintaining healthy, balanced skin
- Price
- $115
ABOUT OUR HYDRO LUXE FACIALS
Reveal your skin's natural glow with our advanced Hydro Luxe Facial, a non-invasive, multi-step treatment designed to deeply cleanse, exfoliate, extract, and hydrate the skin. Perfect for all skin types, this rejuvenating facial uses vortex fusion technology to infuse the skin with nourishing serums while simultaneously removing impurities.
Whether you're targeting dryness, dullness, fine lines, or acne, the Hydro Facial delivers immediate, visible results with zero downtime. Skin looks smoother, brighter, and more youthful after just one session.
HYDRO LUXE FACIAL - $175
Experience the ultimate in skin renewal with our 6-step Hydro Luxe Facial, a powerhouse treatment that deeply cleanses, exfoliates, and hydrates for an instantly refreshed glow.
HYDRO DELUXE FACIAL - $225
Elevate your skincare experience with our 9-step Hydro Deluxe Facial, a comprehensive treatment designed to detoxify, rejuvenate, and deeply nourish your skin for a luminous, youthful glow.
Hydro Facial Services Comparison
| Feature | Hydro Luxe | Hydro Deluxe |
|---|---|---|
| Treatment Steps | 6-step process | 9-step comprehensive treatment |
| Technology | Vortex fusion technology | Advanced vortex fusion with detox |
| Benefits | Deeply cleanses, exfoliates, and hydrates | Detoxifies, rejuvenates, and deeply nourishes |
| Results | Instantly refreshed glow | Luminous, youthful glow |
| Price | $175 | $225 |
- Treatment Steps
- 6-step process
- Technology
- Vortex fusion technology
- Benefits
- Deeply cleanses, exfoliates, and hydrates
- Results
- Instantly refreshed glow
- Price
- $175
Why Choose Luxe Laser for Facial Treatments?
At Luxe Laser & Aesthetics of Woodbridge, Virginia , we believe in working with your skin's natural biology rather than against it. Our exclusive use of Esse Skincare, combined with advanced technology and personalized treatment plans, delivers results that are both immediate and lasting.
- Certified Organic & Vegan
- We exclusively use Esse Skincare, a certified organic, vegan line that supports your skin's natural microbiome for healthier, more resilient skin.
- Microbiome-Friendly Approach
- Unlike conventional skincare, Esse focuses on supporting beneficial microbes that protect, nourish, and balance the skin naturally.
- Advanced Probiotic Technology
- Our treatments use prebiotics, probiotics, and postbiotics to create a healthy environment on the skin's surface.
- Zero Harsh Chemicals
- We work with your skin's natural biology instead of stripping or using harsh chemicals that damage the skin barrier.
- Customized Treatment Plans
- Every facial is tailored to your skin's specific needs, whether dealing with sensitivity, breakouts, dryness, or aging.
- Nature & Science Combined
- We respect your skin's biology while using advanced formulations to promote genuine, lasting health from the inside out.
Experience the Esse Skincare Difference
Our commitment to using only certified organic, vegan, and microbiome-friendly products means your skin receives the purest, most effective care possible. Every treatment is personalized to support your skin's unique needs while promoting long-term health and radiance.
- Certified organic, vegan, & microbiome-friendly products
- Customized treatments for every skin type
- Advanced technology for enhanced results
- Safe for pregnancy & sensitive skin